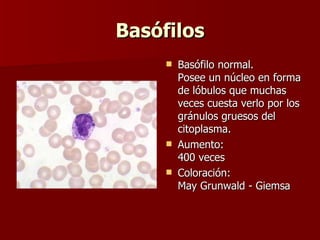
Basófilos Basófilo normal. Posee un núcleo en forma de lóbulos que muchas veces cuesta verlo por los gránulos gruesos del citoplasma. Aumento: 400 veces Coloración: May Grunwald - Giemsa

Este documento describe los diferentes tipos de glóbulos blancos o leucocitos que existen, incluyendo sus funciones y características morfológicas. Explica que existen neutrófilos, linfocitos, eosinófilos, basófilos y monocitos, y proporciona detalles sobre cada uno, como su apariencia bajo el microscopio después de ser teñidos. También incluye valores normales de glóbulos blancos y rojos en adultos y niños, y describe cómo se miden los hematocritos y hemoglobina